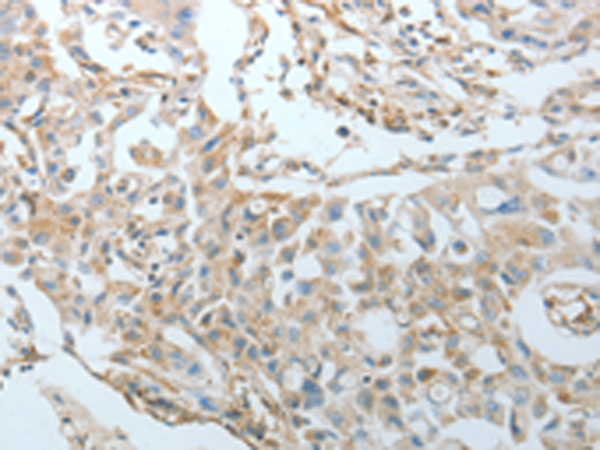

中文名稱:兔抗CRMP1多克隆抗體
|
Background: |
This gene encodes a member of a family of cytosolic phosphoproteins expressed exclusively in the nervous system. The encoded protein is thought to be a part of the semaphorin signal transduction pathway implicated in semaphorin-induced growth cone collapse during neural development. Alternative splicing results in multiple transcript variants. |
|
Applications: |
ELISA, IHC |
|
Name of antibody: |
CRMP1 |
|
Immunogen: |
Fusion protein of human CRMP1 |
|
Full name: |
collapsin response mediator protein 1 |
|
Synonyms: |
DRP1, DRP-1, CRMP-1, DPYSL1, ULIP-3 |
|
SwissProt: |
Q14194 |
|
ELISA Recommended dilution: |
1000-5000 |
|
IHC positive control: |
Human ovarian cancer and human lung cancer |
|
IHC Recommend dilution: |
25-100 |
購物車
購物車 幫助
幫助
 021-54845833/15800441009
021-54845833/15800441009
